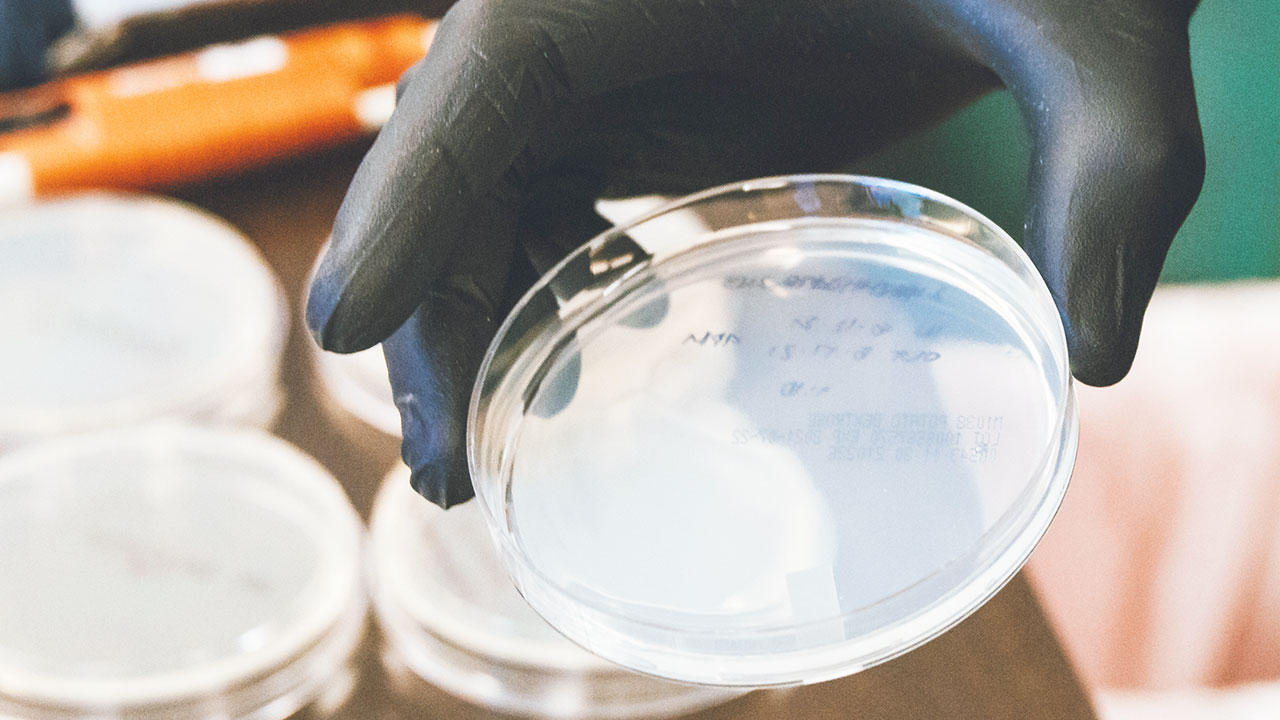
El plástico en los tiempos del residuo cero

El sector de la tecnología médica en Tailandia se desarrolla muy dinámicamente. Un fuerte impulsor de este desarrollo es el turismo médico de los países vecinos, por lo que el gobierno respalda las inversiones que ayudan a este país para convertirse en un centro médico para Asia.
Los proveedores de equipos se benefician en consecuencia. En particular, los consumibles y los accesorios de diagnóstico, como las puntas de pipeta.
Debido a que las puntas de pipeta se usan en sistemas analíticos totalmente automáticos, la calidad reproducible del producto es la máxima prioridad. Para combinar un proceso estable con una alta eficiencia, ENGEL presenta la máquina de moldeo por inyección e victory 170/80 sin barra de amarre con 800 kN de fuerza de sujeción, una unidad de fijación hidráulica y una unidad de inyección eléctrica, con un molde de precisión de 32 cavidades hotrunner por Wellmei (Dongguan, China) y una automatización de alta velocidad de Waldorf Technik (Engen, Alemania).
Como no hay barras de unión en el camino, las platinas de montaje de moldes en las máquinas e-victory se pueden utilizar por completo hasta sus bordes. Esto permite la instalación de moldes grandes de cavidades múltiples en máquinas de moldeo por inyección comparativamente pequeñas, manteniendo bajos los costos de inversión y operación.